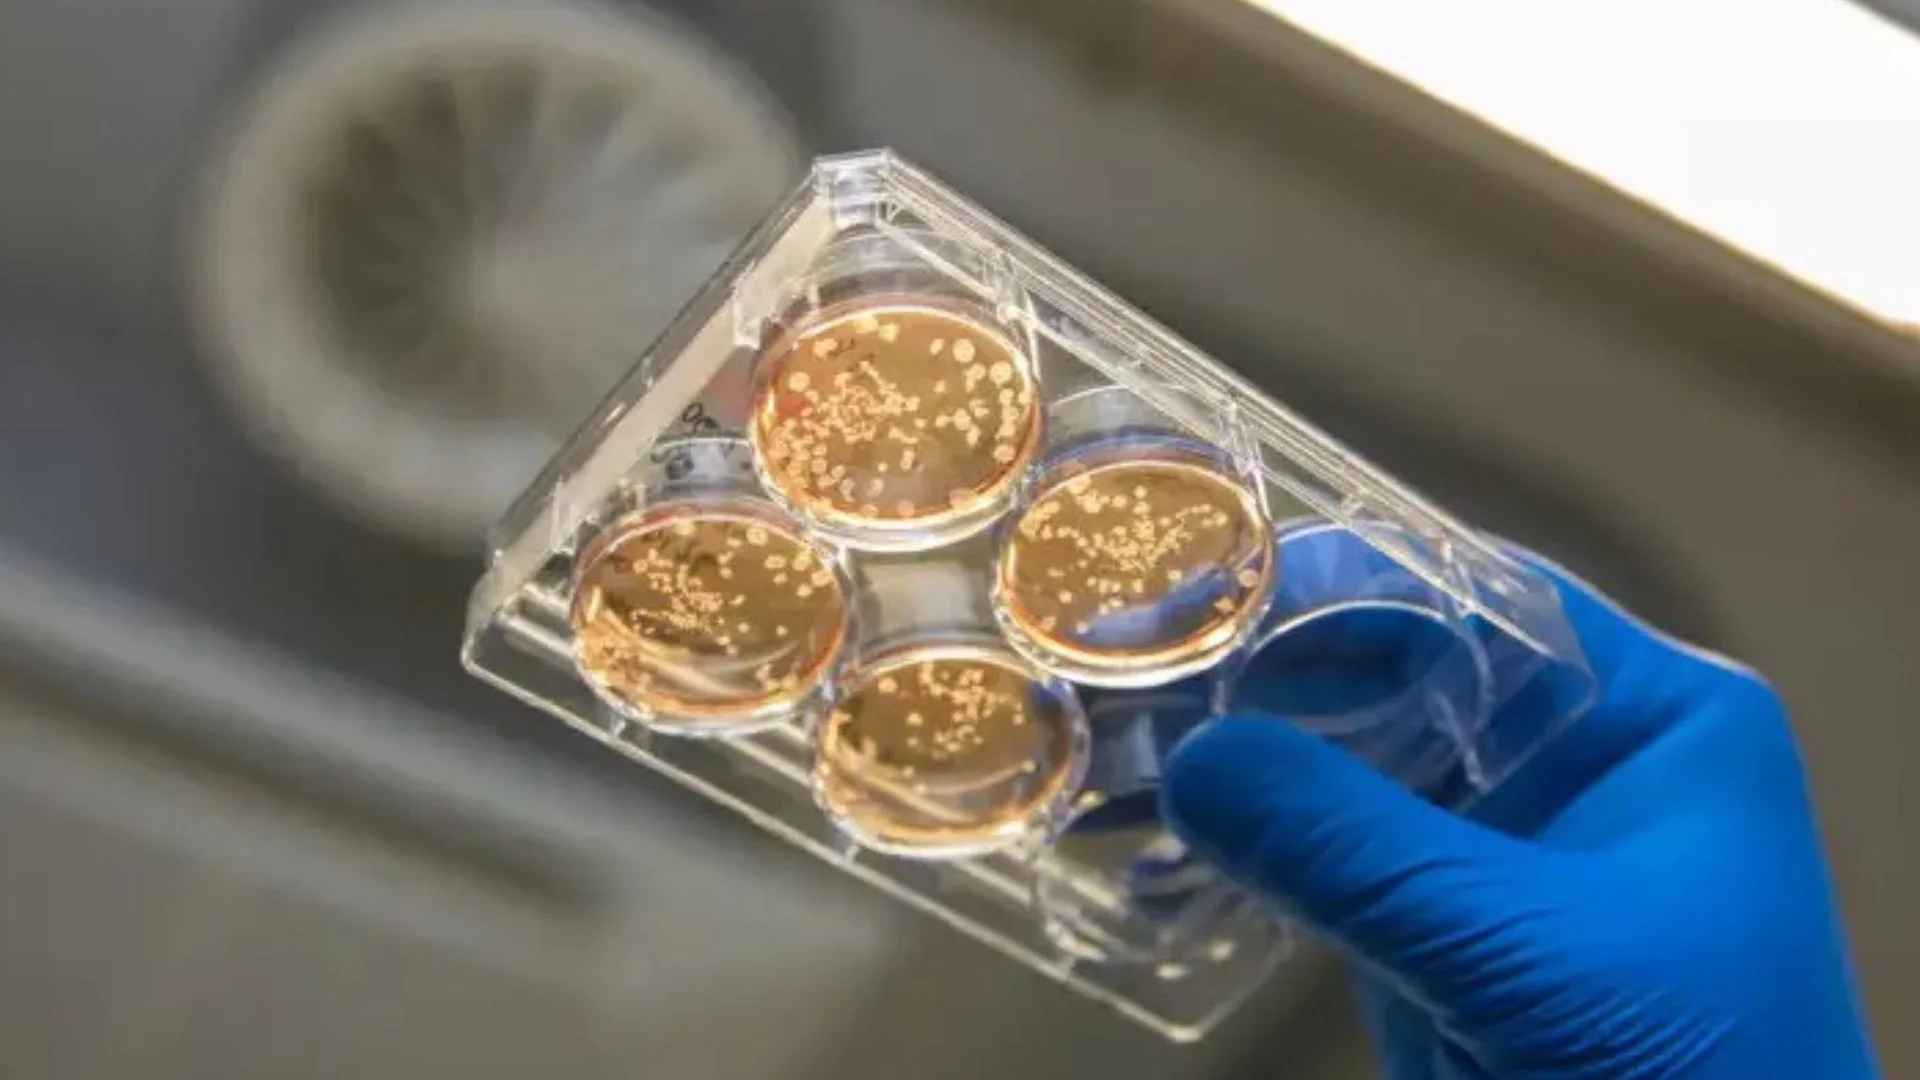
bioreactor system

Researchers in Germany have developed a new way to produce human immune cells at scale, using a specially designed bioreactor system.
The method, developed at Hannover Medical School, enables scientists to generate millions of macrophages per week, opening new doors for medical research and the development of treatments.
The study, published in Nature Protocols, focuses on macrophages, a type of immune cell often called ‘scavenger cells.’ These cells play a vital role in the body. They fight infections, remove harmful substances, and help repair damaged tissues.
READ ALSO: MirrorBot Reveals What Happens When Strangers Finally Look Up
Doctors are already using macrophages in some therapies, including treatments for liver disease. Researchers are now exploring their use in tackling infections, inflammation, fibrosis, cancer, and brain disorders such as Alzheimer’s.
To create these cells, scientists used induced pluripotent stem cells, also known as iPS cells. These are adult cells that have been reprogrammed in the lab to develop into almost any cell type in the body.
While macrophages have been produced before, the process has either been too small for meaningful research or too large and complex for flexible studies. This new system fills that gap.
WATCH ALSO: Humanoid robot plays table tennis like human beings
The team, led by Nico Lachmann, designed medium-sized bioreactors that are efficient, affordable, and easier to use. These bioreactors allow stem cells to grow and organize into small structures called organoids within about 14 days. These organoids behave like bone marrow and continuously release macrophages into the surrounding environment.
“We can harvest up to 40 million immune cells per bioreactor every week over a period of 10 weeks,” says Lachmann.
Each device combines four bioreactors, increasing output while keeping the system compact. This makes it especially useful for preclinical research, where scientists need reliable and scalable cell production without the complexity of industrial setups.
READ ALSO: B-21 Raider Reveals Hidden Design In First Overhead Image During Secret Trials
Beyond research, these lab-grown macrophages could help test new drugs for safety and effectiveness. They may also support the development of cell-based therapies in the future.
The new bioreactor system stands out for its balance, large enough to produce meaningful results, yet simple enough to be widely adopted. For scientists studying the immune system, it offers a steady and powerful new tool.